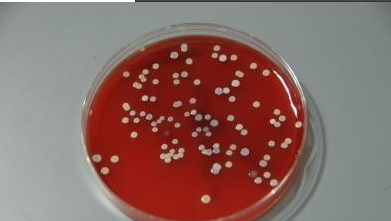

友情提示:石家庄明德中医院是一家著名的石家庄牛皮癣治疗中心,要想治疗牛皮癣,不妨来这里看看,电话:0311-66179120 顽固性皮肤病久拖不愈会增加治疗难度,专家提醒得了牛皮癣就要早就医早治疗
细菌感染会引发牛皮癣吗?细细菌存在于我们生活工作的环境中,能够引起人体的许多疾病。在牛皮癣皮损上并不存在细菌繁殖感染的情况。目前我国大约有300万名牛皮癣患者,牛皮癣是一种常见的慢性皮肤病,国内外对本病的病因和发病机理都做了很多研究,虽然取得了一定成绩,但至今尚未得出肯定的结论。那么牛皮癣的病因有哪些方面呢?下面我们来通过石家庄明德中医院专家对相关问题进行详细的了解。
细菌感染会引发牛皮癣吗
首先就是细菌感染的因素。细菌感染的因素有很多,其中比较常见的有如慢性咽炎,慢性鼻炎,扁桃体炎等。上呼吸道感染等等,都是牛皮癣的复发因素。此外还有的免疫交叉反应的感染,以及机体免疫能力的下降,都是引发牛皮癣的原因。
现在部分医学机构有所共识,牛皮癣是一种身心疾病。所以负面的心理因素也是牛皮癣的患病诱因。现如今城市生活压力的加大,会使工作中的人们精神过于紧张,而长期处于这种状态,就会使亚健康的人们患上牛皮癣的几率大大增加。
此外,皮肤损伤也会引起牛皮癣。据相关统计,皮肤损伤引起牛皮癣的发病率约为0.7%~6%,所以皮肤受到损伤也是引发牛皮癣的原因之一。所以专家在这里告诉大家,当我们的皮肤发生损伤时,一定要及时处理伤口,以免因处理不当造成一些不良后果。
最后,一些环境因素也会引发牛皮癣。比如辐射、光线等等。现如今环境的污染比较严重。有资料表明:环境严重污染明显高于其他地区。很多人就是在不良的环境中引发的牛皮癣。所以想要预防牛皮癣的发病,我们也要注意身边的环境做起。
咨询电话:0311-66179120
地址:红旗大街241号(槐安路与红旗大街交叉口往南走400米,路东)
市内乘坐107路,14路,15路,311路,48路,78路,93路,夜观光2路到 风机厂(明德中医院) 下车即到
咨询电话:0311-66179120
地址:红旗大街241号(槐安路与红旗大街交叉口往南走400米,路东)
市内乘坐107路,14路,15路,311路,48路,78路,93路,夜观光2路到 风机厂(明德中医院) 下车即到
相信通过石家庄明德中医院专家的详细讲解,您对细菌感染与牛皮癣的关系有了详细的了解。希望通过我们的讲解,会对您有所帮助。如果您还对相关问题有什么疑问,请及时的联系我们的在线专家,或者到我们的医院就诊,相信通过我们一流的医疗技术,让您早日摆脱牛皮癣的困扰。
上一篇:女性患牛皮癣的因素有哪些?
下一篇: 石家庄牛皮癣治疗中心,重症牛皮癣的病因?
好技术